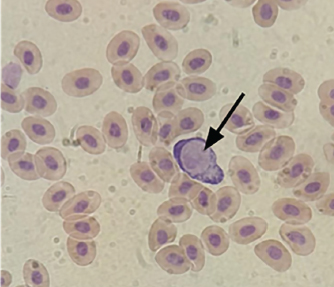

| Research Article | ||
Open Vet. J.. 2025; 15(4): 1557-1564 Open Veterinary Journal, (2025), Vol. 15(4): 1557-1564 Research Article Leucocytozoon caulleryi discovery utilizing indirect-ELISA in East Java, Indonesia as a new approach in detecting leucocytozoonosisEndang Suprihati1*, Lucia Tri Suwanti1, Poedji Hastutiek1, Nunuk Dyah Retno Lastuti1, Akira Ito2 and Naomi Himeno21Division of Veterinary Parasitology, Faculty of Veterinary Medicine, Universitas Airlangga, Surabaya, Indonesia 2Hokkaido Green Pharma Co., Ltd, Sapporo, Japan *Corresponding Author: Endang Suprihati. Division of Veterinary Parasitology, Faculty of Veterinary Medicine, Universitas Airlangga, Surabaya, Indonesia. Email: endang-s [at] fkh.unair.ac.id Submitted: 28/10/2024 Accepted: 15/03/2025 Published: 30/04/2025 © 2025 Open Veterinary Journal
AbstractBackground: Leucocytozoonosis, caused by Leucocytozoon caulleryi, is a significant parasitic disease in poultry and can cause substantial economic losses in the broiler chicken industry while the golden standard of examination is currently absent. Aim: This study aimed to detect the presence of L. caulleryi in broiler chickens in East Java Province using two different diagnostic methods. Methods: Blood samples were taken from the brachial vein of death broiler chickens from several farms recorded as endemic areas of leucocytozoonosis in East Java, Indonesia. Parasite detection was performed by parasitological examination (blood smear) and ELISA serological examination. Results: The results showed a prevalence of L. caulleryi was 13.43% based on blood smear examination, whereas ELISA serological examination showed a higher prevalence (27.78%). This difference in results indicates that serological tests have a higher sensitivity in detecting L. caulleryi infections than parasitological methods. Conclusion: These findings emphasize the importance of using appropriate diagnostic methods to control leucocytozoonosis in broiler chicken farms. Furthermore, the results of this study can serve as a basis for developing more effective control strategies against this disease in East Java Province. Keywords: Blood smear, Broiler chickens, ELISA, Leucocytozoon caulleryi, Prevalence. IntroductionLeucocytozoon is a blood protozoan parasite belonging to the Plasmodiidae family, which affects poultry. In broiler chickens, L. caulleryi is a highly pathogenic protozoan, transmitted by the bites of Culicoides spp., and is common in several Asian countries, including Indonesia (Nakamura, 2022). In the poultry industry, the emergence of Leucocytozoonosis in broiler chickens poses a serious threat, potentially causing death, significant losses in the form of decreased body weight and chicken meat quality, and a sharp decline in production by approximately 30% in laying hens (Zerjal et al., 2021). Losses due to Leucocytozoonosis attacks are often significant in endemic areas because cases of this disease appear throughout the year. The prevalence in laying hens can reach 40%, and generally, Leucocytozoonosis occurs in chickens aged 25–30 days (Elbestawy et al., 2021). Cases of Leucocytozoonosis in broiler chickens appear in several endemic areas in Indonesia, particularly East Java, Central Java, and South Kalimantan, with varying severity levels. To date, the distribution of Leucocytozoonosis cases is still frequently found in several broiler chicken farms in Central Java (67%) and East Java (32%) (Suprihati and Yuniarti, 2017a). The categorization of these endemic areas is certainly inseparable from environmental conditions that support vector development. Vector population dynamics tend to increase during transitions from rainy to dry seasons and vice versa. More than 30% of leucocytozoonosis cases in broiler chickens are recorded in endemic areas of East Java, and more than 60% are recorded in Central Java, whereas updated incidence rates in local chickens and other poultry commodities have not been reported in detail (Suprihati and Yuniarti, 2017b). In general, chicken farms in Indonesia still use open housing systems, which is one of the very potential risk factors for L. caulleryi infection, the most pathogenic Leucocytozoon species affecting chickens (Yu et al., 2000). L. caulleryi is transmitted by blood-sucking Culicoides flies, whereas the other species are transmitted by Simulium (Žiegytė and Bernotienė, 2022). Broiler chicken farms with poor cages and environmental sanitation trigger the proliferation of Culicoides vectors (Hinkle and Corrigan, 2020). Chickens affected by leucocytozoonosis (Malaria-like disease) do not show clear clinical symptoms (Schumm et al., 2019), so the detection of leucocytozoonosis in chickens in efforts to control this disease requires support from rapid laboratory examinations that can handle large numbers of samples. Currently, Indonesia has no gold standard for the detection of leucocytozoonosis. Commonly used methods for detecting leucocytozoonosis are polymerase chain reaction (PCR) and conventional blood smear under a microscope. These approaches are direct but bring limitations. Blood smears sometimes fail to detect parasites in cases of low parasitemia, especially because the gametocyte stage of this parasite is only present in the blood circulation for an interval of one week (Steele and Noblet, 1993). Identification of Leucocytozoon spp. based on morphology often cannot determine the species level due to the extensive morphological variations, making it difficult to characterize the parasite morphology if relying solely on microscopic examination. However, PCR is expensive for the detection of many samples (Bourgeois et al., 2010). Therefore, early detection often fails to mitigate outbreaks. To address these limitations, there is a pressing need for the development and application of less costly diagnostic methods with high accuracy and sensitivity in Indonesia. Serological approaches, particularly enzyme-linked immunosorbent assay (ELISA), offer several advantages. ELISA has never been implemented for Leucocytozoonosis detection in Indonesia due to the absence of kits despite its advantages regardless of parasitemia (Stanker and Hnasko, 2015). Its high-throughput capability allows for the simultaneous analysis of a large number of samples, making it suitable for widespread screening and epidemiological studies. ELISA also demonstrates sensitivity across infection stages, potentially detecting infections ranging from low to high parasitemia levels, making it applicable to both acute and chronic infection conditions (Chawengkirttikul et al., 2021). Furthermore, with the development of species-specific antigens, ELISA could potentially overcome the limitations of morphological identification, allowing for more accurate species-level diagnosis. Given the significant impact of Leucocytozoonosis on the Indonesian poultry industry and the limitations of current diagnostic methods, future research should focus on several key areas. Developing and optimizing ELISA-based diagnostic kits specific for L. caulleryi and other relevant Leucocytozoon species affecting poultry in Indonesia is crucial. Conducting comprehensive mapping studies using both parasitological and serological tests to determine the detailed distribution of L. caulleryi infections in broiler chickens across various regions of East Java and other affected areas is essential. By addressing these research gaps and implementing more sophisticated diagnostic approaches, this study is the first to reveal the effectiveness of an indirect ELISA for leucocytozoonosis detection, suggesting an effective method for leucocytozoonosis detection in Indonesia. Materials and MethodsThis study was conducted between July and December 2023. This cross-sectional study implemented purposive sampling in areas that had been determined as endemic for leucocytozoonosis (Suprihati, 2013). Ethical approvalThis research used dead animals that did not necessarily pass ethical clearance from the Animal Use Committee as all animals were brought by farmers to report the case to our university. Blood samples were collected from reported dead chickens with leucocytozoonosis pathological symptoms from nine farms in nine different districts of East Java Province, with 24 blood samples taken from each district delivered to the Laboratory of Veterinary Parasitology, Faculty of Veterinary Medicine, Universitas Airlangga for parasitological examination and Laboratory of biomolecular, Faculty of Veterinary Medicine, Universitas Airlangga for serological examination. Parasitological examinationBlood samples (125 μl) were collected from the brachial vein using a heparinized tuberculin syringe and transported to the Laboratory of Veterinary Parasitology, where analyses were performed. During transport, the samples were stored in an icebox until processing. The samples were then examined and blood smears were prepared, air dried, and fixed with absolute methanol, and stained with Giemsa (Sigma-Aldrich, St. Louis, MO, USA). Microscopic examination of the blood smears was performed at 1000× magnification with a CDC camera (DP70) using an Olympus BX51 microscope (Olympus Corp., Tokyo, Japan) (Svobodová et al., 2023). Serological examination ELISAThe blood samples were collected from the brachial vein and centrifuged (2,500 RPM for 10 minutes) to obtain serum and stored at —80°C until analyses (Kong et al., 2021). The serological examination was performed by testing serum samples containing L. caulleryi antibodies reacted with an antigen kit. The indirect ELISA procedure began by coating the blood protozoan parasite L. caulleryi antigen at a concentration of 2 μg/ml, applying 100 μl/well to the microplate diluted 1/100 using coating buffer, and incubating at 4°C for approximately 18 hour. The microplate was washed with washing buffer (physiological NaCl and 0.5 ml triton) 200 μl/well 3 times for 1 minute each. The microplate was blocked with 4% milk-blocking solution at 100 μl/well and incubated at 37°C for 1 hour. Next, the microplate was washed with washing buffer (physiological NaCl and 0.5 ml triton) 200 μl/well 3 times for 1 minute each. Antibodies resulting from L. caulleryi blood protozoa infection were diluted 1/500 with blocking buffer, then 100 μl/well was added and incubated for 1 hour at 37°C, after which the microplate was washed with washing buffer (physiological NaCl and 0.5 ml triton) 200 μl/well 3 times for 1 minute each, followed by the addition of conjugate (Anti-chicken IgG labeled with alkaline phosphatase enzyme) diluted with blocking buffer at 1:10000 dilution, 100 μl/well, and incubated for one hour at 37°C. Next, the microplate was washed again with washing buffer (physiological NaCl and 0.5 ml triton) 200 μl/well 3 times for 1 minute each, then 100 μl of p-NPP substrate was added to all wells, covered with aluminum foil, and left for 30 minutes in a dark room. Immediately thereafter, 50 μl of 3N NaOH was added to each well to stop the reaction. The results were read using an ELISA reader at a wavelength of 405 nm. The optical density (OD) value was obtained as the result of this study (Honjo et al., 2022). Statistical resultPrevalence from ELISA and parasitological examination were compared by using an independent T-test in SPSS. ResultsBased on both parasitological and serological examinations, the prevalence data of L. caulleryi in various broiler chicken farms in East Java Province are shown in Table 1. The total prevalence of L. caulleryi in the parasitological test (13.43%) was lower than that in the ELISA serological test (27.78), see (Table 1). The difference in the prevalence rates of L. caulleryi found between blood smear examination (parasitological method) and ELISA serological test in broiler chicken farms statistically shows 0.058. Gresik showed the largest difference in prevalence between the two methods, with blood smear detecting 20.83% of cases, while ELISA detected 50%. This 29.17% difference indicates that blood smear failed to identify over half of the infections detected by ELISA. Similarly, Mojokerto had a 25% difference, with blood smear detecting 16.67% of cases compared to 41.67% by ELISA. Lamongan had the highest prevalence overall, with Blood Smear detecting 33.33% of cases and ELISA detecting 54.17%. These results highlight the limitations of Blood Smear in detecting latent or chronic infections, which are more accurately identified by ELISA. Table 1. Comparison of prevalence of L. caulleryi in broiler chicken farms in East Java Province based on Blood Semar and ELISA.
Fig. 1. Gamet of Leucocytozoon caulleryi (Olympus BX-51 microscope with 1000× magnification; CDC camera (DP70)). Other regions, such as Bojonegoro and Tuban, showed lower infection rates but still differences between the two methods. Bojonegoro had a 12.50% difference, with ELISA detecting 16.67% of cases compared to 4.17% by blood smear. Tuban showed an 8.33% difference, with ELISA detecting 12.50% of cases, while blood smear detected only 4.17%. In contrast, Jombang and Jember showed no positive cases with either method. Blitar, however, had a relatively high prevalence, with ELISA detecting 50% of cases compared to 29.17% by Blood Smear. These findings demonstrate that ELISA consistently detects more infections than blood smear across various regions. Blood smear examination is a direct method for detecting the presence of parasites in blood cells. This method relies on microscopic visualization of parasites in blood samples taken (Maqsood et al., 2021). The results of the parasitological examination of L. caulleryi are shown in Figure 1. However, this method has several limitations that can lead to lower prevalence results compared to ELISA serological tests due to its reliance on parasitemia. DiscussionThis study compares the prevalence rate of leucocytozoonosis between blood smear and indirect ELISA detection. Despite not being statistically significant, the result addresses the research purpose that indirect ELISA shows a higher prevalence rate from all regions in Indonesia than those with blood smears. Therefore, this study suggests that indirect ELISA could be a recommended method for leucocytozoonosis detection for two reasons. First, indirect ELISA has higher accuracy and sensitivity, as shown by the higher prevalence rate in each region. Second, despite the different prevalence rates, the two methods showed no contradictory pattern of positive samples, indicating that both methods have no contradiction. From the result, indirect ELISA shows higher sensitivity and accuracy compared to conventional blood smears for the following reasons. Although blood smear has advantages including simplicity, affordability, and direct determination that may give a valid result, it also comes with disadvantages, including a limited period of parasitemia, a fluctuating number of parasites in the blood, and reliance on skillful personnel. The stage of parasitemia in Leucocytozoon, which is a stage of gametocytes, only lasts for seven days and often fluctuates. In addition, the number of parasites in the blood may vary depending on the severity. Gresik, Mojokerto, and Lamongan showed significant differences in the prevalence of L. caulleryi infections between the blood smear and ELISA methods. In Gresik, ELISA detected 50% of cases, while blood smear detected only 20.83%, indicating many latent infections were missed. Mojokerto had a 25% difference, with ELISA detecting 41.67% of cases compared to 16.67% by blood smear. Lamongan, with the highest prevalence, showed ELISA detecting 54.17% of cases, while blood smear detected only 33.33%. This indicates that blood smear is less effective in detecting latent infections, while ELISA is more accurate in identifying subclinical cases. Other regions such as Bojonegoro, Tuban, and Magetan also showed significant differences, albeit with lower infection rates. Bojonegoro had a 12.50% difference, Tuban 8.33%, and Magetan 12.50%, where ELISA detected more cases than blood smear. On the other hand, Jombang and Jember showed no positive cases with either method, likely due to biosecurity or environmental factors that do not support transmission. However, Blitar had a relatively high prevalence, with ELISA detecting 50% of cases compared to 29.17% by blood smear, indicating the need for stronger mitigation strategies. This means that at the time of blood sampling, the number of parasites circulating in the bloodstream may be very low or even undetectable, even though the chicken is infected (Pohuang et al., 2021). The sensitivity of blood smear examination is highly dependent on the examiner’s skill and experience in identifying parasites. If parasitemia is low, the possibility of parasites being missed during examination increases (McPherson and Pincus, 2021). In contrast, indirect ELISA was used to detect the presence of immunoglobulin against the parasite (Isobe and Suzuki, 1986), which is identical to the results of this study. This condition brings advantages to detecting early infection in the near time of schizont rupture as the trigger for antibody production. ELISA can detect infection even when parasites are not visible in blood smears, as antibodies can persist in circulation for a long time after the initial infection. This means that ELISA can detect past infections or chronic infections with low parasitemia (Ndao, 2009). Additionally, ELISA has higher sensitivity compared to blood smear examination, especially in detecting infections at early stages or infections with low parasite loads (Ricciardi and Ndao, 2015). After infection, it takes several days to weeks for the chicken’s immune system to produce detectable antibodies. During this period, blood smear examination may already detect parasites, while ELISA may not yet show positive results (Crespo and Shivaprasad, 2021). However, once antibodies are formed, ELISA will continue to show positive results even after parasites are no longer detectable in the blood. ELISA can detect antibodies from resolved infections where parasites are no longer present in the blood (Ricciardi and Ndao, 2015). This can lead to an overestimation of active infection prevalence but provides a more accurate picture of population exposure to the parasite. In the context of broiler chicken farms, where production cycles are relatively short (Szőllősi et al., 2014), the difference between blood smear examination and ELISA results is more pronounced. Broiler chickens may be exposed to L. caulleryi early in life, and develop antibodies, but may have overcome active infection by the time of examination, so parasites will not be found in blood smear examinations but will be detected in antibody tests using ELISA. The prevalence of Leucocytozoonosis in broiler chicken farms across East Java Province presents a complex interplay of environmental, biological, and management factors. This multifaceted issue demands a nuanced understanding to develop effective control strategies. At the heart of the problem lies the vector, Culicoides spp. flies, which serve as the primary transmission agents for L. caulleryi (Ogbaje et al., 2019). These diminutive yet potent vectors thrive in moist environments, with their breeding grounds often found in water puddles, muddy areas, or decomposing organic matter commonly present in and around farm settings (Uslu and Dik, 2010). The proximity of broiler farms to such habitats significantly elevates the risk of L. caulleryi infection, creating a perpetual cycle of transmission between the vector and host populations. Environmental conditions play a pivotal role in shaping the prevalence of Leucocytozoonosis. The rainy seasons characteristic of East Java’s tropical climate, coupled with high humidity levels, foster ideal breeding conditions for Culicoides spp. This environmental synergy not only supports vector proliferation but also enhances longevity, thereby extending the window of potential disease transmission. Furthermore, the warm temperatures prevalent in the region accelerate parasite development within the vector, a phenomenon that Lata et al. (2018) highlighted as a critical factor for increasing transmission efficiency. This temperature-dependent acceleration of the parasite life cycle underscores the intricate relationship between climate and disease dynamics in poultry farming. The management practices employed in broiler farms emerge as another crucial determinant in the prevalence of Leucocytozoonosis. Suboptimal farm management systems, characterized by poor sanitation, excessive stocking density, and inadequate ventilation, create a stress-laden environment for the chickens. Yohannes and Tekle (2018) emphasize how these stressors can significantly compromise the birds’ immune systems, rendering them more susceptible to L. caulleryi infection. The immunosuppressive effect of poor management practices not only increases the likelihood of initial infection but also potentially exacerbates the severity and duration of the disease, further complicating control efforts. Age-related susceptibility adds another layer of complexity to the Leucocytozoonosis issue in broiler farming. Permin et al. (2002) noted that younger chickens generally exhibit a higher susceptibility to infection, a factor of particular relevance in broiler production. The relatively short lifespan of broiler chickens in commercial settings means that a significant portion of the flock remains in this vulnerable age group throughout most of the production cycle (Van De Weerd et al., 2009). This demographic reality creates a perpetually susceptible population, providing L. caulleryi with a constant pool of potential hosts and contributing to the high prevalence rates observed in East Java’s broiler farms. The control of L. caulleryi in broiler chicken farms requires a multifaceted approach that addresses various aspects of the parasite’s lifecycle and transmission dynamics. Vector control has emerged as a primary focus given the crucial role of Culicoides flies in L. caulleryi transmission. Geden and Hogsette (2001) propose several strategies for vector management, including the reduction of standing water around farms to limit breeding sites, judicious use of insecticides, and the installation of UV light traps to capture nocturnal Culicoides flies. When implemented systematically, these measures can significantly disrupt the vector population and reduce parasite transmission. Concurrent with vector control, improvements in farm management practices are essential for mitigating L. caulleryi prevalence. Galen et al. (2018) emphasized the importance of enhanced cooperative sanitation, appropriate regulation of population density, and provision of adequate nutrition to bolster chicken immunity. These practices not only create an environment less conducive to parasite transmission but also strengthen the host’s resistance to infection. Furthermore, Manuja et al. (2014) underscored the critical role of stringent biosecurity measures in preventing the entry of vectors and pathogens into farm premises, thereby creating a formidable barrier to L. caulleryi introduction and spread. Vaccination is an important preventive method for reducing the prevalence of leucocytozoonosis. A previous study by Suprihati and Yuniarti (2017a) reported that L. caulleryi strains affecting broiler chickens in Indonesia showed high genetic similarity, suggesting that they belong to a single strain. Umali et al. (2014) report that a single dose of the vaccine administered to broiler chickens at 45 days of age can provide antibody protection exceeding 1,600 units when measured by ELISA 56 days post-vaccination. This high antibody titer can persist for up to 126 days, and when a booster dose is administered, the antibody titer doubles. Notably, vaccinated chickens that received booster shots showed no clinical symptoms, either mild or severe, when challenged with Leucocytozoonosis exposure. Given these promising results, the R7 recombinant subunit vaccine can be recommended for use in broiler chicken farms, especially in layer chickens located in Leucocytozoonosis-endemic areas. Through molecular mapping, accurate determination of the Leucocytozoonosis-causing species becomes possible, enabling the development of vaccines in Indonesia based on local L. caulleryi isolates. In high-risk scenarios, the prophylactic use of antiparasitic medications may be warranted. Şimşek et al. (2023) suggest that such interventions can be particularly effective in situations where the risk of infection is elevated. However, this approach should be balanced against concerns of drug resistance and implemented judiciously as part of a broader control strategy. Continuous monitoring and surveillance form another critical component of L. caulleryi control. Zhou et al. (2020) advocated routine blood sample examinations and utilization of molecular diagnostic techniques for the early detection of infections. This proactive approach enables timely intervention and helps prevent the escalation of outbreaks. Additionally, Hinkle and Corrigan (2020) emphasized the importance of farmer education in long-term control strategies. By enhancing farmers’ understanding of parasite biology, vector lifecycles, and best management practices, they become empowered to implement effective preventive measures independently. The integration of these various approaches, as proposed by Ito et al. (2013), offers a comprehensive strategy for controlling L. caulleryi prevalence in broiler chickens. This holistic method not only improves chicken health and productivity, but also mitigates the economic losses associated with the disease. Given the higher prevalence rates detected through ELISA compared to direct parasitological examination, Lilyanna et al. (2018) recommended integrating both methods into routine surveillance and diagnostic programs. This combined approach provides a more complete picture of both current and past infections, thereby enhancing the overall understanding of disease dynamics within a flock. According to Mehlhorn (2016), ELISA shows superiority to other systems as they can indicate the smallest amount of antibody or antigen complexes. To further refine detection methods, future research should explore the variety of different proteins for indirect ELISA-based diagnosis as different molecules may result in different sensitivity (Bashir et al., 2013). this method offers superior sensitivity and specificity, particularly in cases of low-level or chronic infections that might elude detection via traditional blood smears. Moreover, longitudinal studies involving periodic monitoring of broiler populations could provide invaluable insights into infection dynamics and the efficacy of implemented control measures over time. The critical role of vector control in managing Leucocytozoonosis underscores the need for comprehensive entomological surveys. Nakata et al. (2003) advocate for research efforts aimed at identifying and mapping vector distribution patterns in the region. Such data would be instrumental in developing targeted and effective vector control strategies tailored to local ecological conditions. Additionally, further investigation into the environmental risk factors and farm management practices contributing to L. caulleryi prevalence is warranted. This research could inform the development of more nuanced and effective control approaches, addressing the root causes of disease spread in East Java’s broiler industry. Finally, given the potential economic ramifications of Leucocytozoonosis on the poultry sector, a thorough cost-benefit analysis of various control strategies is advisable. This analysis should encompass a range of interventions, including vaccination programs, environmental management techniques, and treatment regimens. By providing a clear economic perspective on different control options, such research would equip farmers and policymakers with the necessary information to make informed decisions for effective and efficient disease management in East Java Province’s broiler chicken industry. Based on the research conducted using two different methods, the prevalence of L. caulleryi was found to be 24.07% through parasitological examination (blood smear) and 27.78% through serological examination (ELISA). The significant disparity between ELISA and Blood Smear results indicates that many L. caulleryi infections are subclinical or latent, making them undetectable by microscopic methods. Blood Smear is only effective in detecting active parasitemia, while ELISA can identify antibody responses, including in infections without clinical symptoms. These results indicate that the ELISA serological method has a higher sensitivity in detecting L. caulleryi infection compared to the parasitological method. This phenomenon explains why high-prevalence areas such as Gresik, Mojokerto, and Lamongan show large discrepancies between the two methods. Additionally, environmental factors such as the presence of vectors and farming conditions may contribute to the high rate of latent infections in these regions. Therefore, the use of ELISA as the primary diagnostic tool is crucial for uncovering the true disease burden and designing more effective control strategies. This finding provides important information for efforts to control leucocytozoonosis in broiler chickens in East Jawa, Indonesia, and emphasizes the importance of using appropriate detection methods in the surveillance of this disease. AcknowledgmentsThe author would like to express gratitude to all the faculty members of the Faculty of Veterinary Medicine at Universitas Airlangga for their technical involvement and Hokkaido Green Pharma Co., Ltd. FundingThis research was funded by the Universitas Airlangga, and the detection kit was supported by Hokkaido Green Pharma Co., Ltd. Authors’ contributionAll authors have dedicated their contribution and played their role accordingly and distributed fairly. Conflict of interestThe authors declared that there is no conflict of interest in this article. Data availabilityData is available in Table 1. ReferencesBashir, I.M., Otsyula, N., Awinda, G., Spring, M., Schneider, P. and Waitumbi, J.N. 2013. Comparison of Pf HRP-2/p LDH ELISA, qPCR and microscopy for the detection of Plasmodium events and prediction of sick visits during a malaria vaccine study. PLoS One 8, e56828. DOI: 10.1371/journal.pone.0056828 Bourgeois, N., Boutet, A., Bousquet, P. J., Basset, D., Douard-Enault, C., Charachon, S. and Lachaud, L. 2010. Comparison of three real-time PCR methods with blood smears and rapid diagnostic test in Plasmodium sp. infection. Clin. Microb. Infect. 16, 1305–1311. DOI: 10.1111/j.1469-0691.2009.02933.x Chawengkirttikul, R., Junsiri, W., Watthanadirek, A., Poolsawat, N., Minsakorn, S. and Anuracpreeda, P. 2021. Molecular detection and genetic diversity of Leucocytozoon sabrazesi in chickens in Thailand. Sci. Rep. 11, 16686. DOI: 10.1038/s41598-021-96241-7 Crespo, R. and Shivaprasad, H.L. 2021. Interpretation of laboratory results and values. Backyard poultry medicine and surgery: a guide for veterinary practitioners. Hoboken, NJ: Wiley Blackwell. DOI: 10.1002/9781119511816.ch27 Elbestawy, A.R., Ellakany, H.F., Abd El-Hamid, H.S., Gado, A.R., Geneedy, A.M., Noreldin, A.E. and Salaheldin, A.H. 2021. Leucocytozoon caulleryi in broiler chicken flocks: clinical, hematologic, histopathologic, and molecular detection. Avian Dis. 65, 407–413. DOI: 10.1637/0005-2086-65.3.407 Galen, S.C., Nunes, R., Sweet, P.R. and Perkins, S.L. 2018. Integrating coalescent species delimitation with analysis of host specificity reveals extensive cryptic diversity despite minimal mitochondrial divergence in the malaria parasite genus Leucocytozoon. BMC Evol. Bio. 18, 1–15. DOI: 10.1186/s12862-018-1242-x Geden, C.J. and Hogsette, J. 1994. Research and extension needs for integrated pest management for arthropods of veterinary importance. Maryland: USDA-ARS. Hinkle, N.C. and Corrigan, R.M. 2020. External parasites and poultry pests. Diseases of poultry. Hoboken, NJ: Wiley Blackwell. DOI: 10.1002/9781119371199.ch26 Honjo, Y., Fukumoto, S., Sakamoto, H. and Hikosaka, K. 2022. New PCR primers targeting the cytochrome b gene reveal diversity of Leucocytozoon lineages in an individual host. Par. Res. 121, 3313–3320. DOI: 10.1007/s00436-022-07667-5 Isobe, T. and Suzuki, K. 1986. Enzyme-linked immunosorbent assay for detection of antibody to Leucocytozoon caulleryi. Avian Pathol. 15, 199–211. DOI: 10.1080/03079458608436281 Ito, A., Gotanda, T., Himeno, N., Itchoda, N., Tabayashi, N., Ike, K. and Matsumura, T. 2013. Booster responses by oral vaccination with transgenic plants against chicken leucocytozoonosis. Avian Pathol. 42, 215–220. DOI: 10.1080/03079457.2013.779635 Kong, F., Zhao, G., He, Z., Sun, J., Wang, X., Liu, D. and Wen, J. 2021. Serum creatine kinase as a biomarker to predict wooden breast in vivo for chicken breeding. Front. Phys. 12, 1–7. DOI: 10.3389/fphys.2021.711711 Lata, K., Das, G., Verma, R. and Baghel, R.P.S. 2018. Impact of climate variability on occurrence and distribution of vector and vector-borne parasitic diseases. J. Entomol. Zool. 6, 1388–1393. Lilyanna, S., Ng, E.M.W., Moriguchi, S., Chan, S.P., Kokawa, R., Huynh, S.H. and Liew, O.W. 2018. Variability in microplate surface properties and its impact on ELISA. J. App. Lab. Med. 2, 687–699. DOI: 10.1373/jalm.2017.023952 Manuja, B.K., Manuja, A. and Singh, R.K. 2014. Globalization and livestock biosecurity. Agri. Res. 3, 22–31. DOI: 10.1007/s40003-014-0097-7 Maqsood, A., Farid, M.S., Khan, M.H. and Grzegorzek, M. 2021. Deep malaria parasite detection in thin blood smear microscopic images. App. Sci. 11, 2284. DOI: 10.3390/app11052284 McPherson, R.A. and Pincus, M.R. 2021. Henry’s clinical diagnosis and management by laboratory methods E-book. Amsterdam, Netherlands: Elsevier Health Sciences. Mehlhorn, H. 2016. Animal parasites: diagnosis, treatment, prevention. Berlin: Springer. Nakamura, K. 2022. Leucocytozoon caulleryi infection in chickens: etiology, pathology, and diagnosis. JARQ 56, 121–127. DOI: 10.6090/jarq.56.121 Nakata, K., Watarai, S., Kodama, H., Gotanda, T., Ito, A. and Kume, K. 2003. Cellular immune responses in chickens induced by recombinant R7 Leucocytozoon caulleryi vaccine. J. Par. 89, 419–422. DOI: 10.1645/0022-3395(2003)089[0419:CIRICI]2.0.CO;2 Ndao, M. 2009. Diagnosis of parasitic diseases: old and new approaches. Inter. Pers. Infec. Dis. 2009, 278246. DOI: 10.1155/2009/278246 Ogbaje, C.I., Okpe, J.A. and Oke, P. 2019. Haemoparasites and haematological parameters of Nigerian indigenous (local) and Exotic (broiler) chickens slaughtered in Makurdi Major Markets, Benue State, Nigeria. Alex. J. Vet. Sci, 63, 90–96. DOI: 10.5455/ajvs.53637 Opara, M.N., Osowa, D.K. and Maxwell, J.A. 2014. Blood and gastrointestinal parasites of chickens and turkeys reared in the tropical rainforest zone of southeastern Nigeria. Open J. Vet. Med. 4, 308–313. DOI: 10.4236/ojvm.2014.412037 Permin, A., Esmann, J.B., Hoj, C.H., Hove, T. and Mukaratirwa, S. 2002. Ecto-, endo-and haemoparasites in free-range chickens in the Goromonzi District in Zimbabwe. Prev. Vet. Med. 54, 213–224. DOI: 10.1016/S0167-5877(02)00024-7 Pohuang, T., Jittimanee, S. and Junnu, S. 2021. Pathology and molecular characterization of Leucocytozoon caulleryi from backyard chickens in Khon Kaen Province, Thailand. Vet. World. 14, 2634–2639. DOI: 10.14202/vetworld.2021.2634-2639 Ricciardi, A. and Ndao, M. 2015. Diagnosis of parasitic infections: what’s going on? J. Biomed. Screen. 20, 6–21. DOI: 10.1177/1087057114548065 Schumm, Y.R., Wecker, C., Marek, C., Wassmuth, M., Bentele. A., Willems, H. and Quillfeldt, P. 2019. Blood parasites in Passeriformes in central Germany: prevalence and lineage diversity of Haemosporida (Haemoproteus, Plasmodium and Leucocytozoon) in six common songbirds. PeerJ. 6, e6259. DOI: 10.7717/peerj.6259 Şimşek, R., Farooqui, A., Khan, S.U.D. and Khan, S. 2023. Introduction: back to the future-solutions for parasitic problems. in Parasitic Infections: Immune Responses and Therapeutics, Eds., Mishra, A.B. and Nigam, M. Hoboken, NJ: Wiley. DOI: 10.1002/9781119878063.ch1 Stanker, L.H. and Hnasko, R.M. 2015. A double-sandwich ELISA for identification of monoclonal antibodies suitable for sandwich immunoassays. ELISA: methods and protocols. Totowa: Humana Press. DOI: 10.1007/978-1-4939-2742-5_7 Steele, E.J. and Noblet, G.P. 1993. Gametocytogenesis of Leucocytozoon smithi. J. Euk. Microb. 40, 384–391. DOI: 10.1111/j.1550-7408.1993.tb04932.x Suprihati, E. and Yuniarti, W.M. 2017a. Variasi Morfologi dan Deteksi Leucocytozoon caulleryi dengan Metode PCR pada Ayam Ras di Wilayah Endemis Indonesia. JSV. 35, 175–183. DOI: 10.22146/jsv.34666 Suprihati, E. and Yuniarti, W.M. 2017b. The phylogenetics of Leucocytozoon caulleryi infecting broiler chickens in endemic areas in Indonesia. Vet. World. 10, 1324–1328. DOI: 10.14202/vetworld.2017.1324-1328 Suprihati, E. 2013. Analisis filogenetika gen cytochrom B Leucocytozoon Spp. Pada Ayam Ras Di Wilayah Endemis Indonesia. Thesis, Universitas Airlangga Svobodová, M., Čepička, I., Zídková, L., Kassahun, A., Votýpka, J., Peške, L. and Weidinger, K. 2023. Blood parasites (Trypanosoma, Leucocytozoon, Haemoproteus) in the Eurasian sparrowhawk (Accipiter nisus): diversity, incidence and persistence of infection at the individual level. Par. Vec.16, 15. DOI: 10.1186/s13071-022-05623-x Szőllősi, L., Szűcs, I. and ábrádi, A. 2014. Economic issues of broiler production length. Економика пољопривреде 61, 633–646. DOI: 10.5937/ekopolj1403633s Umali, D.V., Ito, A., Valle, F.P.D., Shirota, K. and Katoh, H. 2014. Antibody response and protective immunity of chickens vaccinated with booster dose of recombinant oil-adjuvanted Leucocytozoon caulleryi subunit vaccine. Avian Dis. 58, 609–615. DOI: 10.1637/10829-032714-reg Uslu, U. and Dik, B. 2010. Chemical characteristics of breeding sites of Culicoides species (Diptera: Ceratopogonidae). Vet. Par. 169, 178–184. DOI: 10.1016/j.vetpar.2009.12.007 Van De Weerd, H.A., Keatinge, R. and Roderick, S. 2009. A review of key health-related welfare issues in organic poultry production. World’s Poultry Sci. J. 65, 649–684. DOI: 10.1017/s0043933909000464 Yohannes, G. and Tekle, Y. 2018. Review on health care management practices in poultry | biosecurity; health care management; poultry; sanitation; vaccination [Internet]. Available via Kenkyugroup.org (accessed 11th August, 2024). Yu, C.Y., Wang, J.S. and Yeh, C.C. 2000. Culicoides arakawae (Diptera: Ceratopogonidae) population succession in relation to leucocytozoonosis prevalence on a chicken farm in Taiwan. Vet. Par. 93, 113–120. DOI: 10.1016/s0304-4017(00)00362-9 Zerjal, T., Härtle, S., Gourichon, D., Guillory, V., Bruneau, N., Laloë, D. and Quéré, P. 2021 Assessment of trade-offs between feed efficiency, growth-related traits, and immune activity in experimental lines of layer chickens. Gen. Select. Evo. 53, 44–61. DOI: 10.1186/s12711-021-00636-z Zhou, Z., Shen, B. and Bi, D. 2020. Management of pathogens in poultry. In Animal agriculture (pp. 515–530). Cambridge, MA: Academic Press. DOI: 10.1016/b978-0-12-817052-6.00030-6 Žiegytė, R. and Bernotienė, R. 2022. Contribution to the knowledge on black flies (Diptera: Simuliidae) as vectors of Leucocytozoon (Haemosporida) parasites in Lithuania. Parasitol. Int. 87, 102515. DOI: 10.1016/j.parint.2021.102515-8 | ||
| How to Cite this Article |
| Pubmed Style Suprihati E, Suwanti LT, Hastutiek P, Lastuti NDR, Ito A, Himeno N. Leucocytozoon caulleryi discovery utilizing indirect-ELISA in East Java, Indonesia as a new approach in detecting leucocytozoonosis. Open Vet. J.. 2025; 15(4): 1557-1564. doi:10.5455/OVJ.2025.v15.i4.6 Web Style Suprihati E, Suwanti LT, Hastutiek P, Lastuti NDR, Ito A, Himeno N. Leucocytozoon caulleryi discovery utilizing indirect-ELISA in East Java, Indonesia as a new approach in detecting leucocytozoonosis. https://www.openveterinaryjournal.com/?mno=226386 [Access: January 24, 2026]. doi:10.5455/OVJ.2025.v15.i4.6 AMA (American Medical Association) Style Suprihati E, Suwanti LT, Hastutiek P, Lastuti NDR, Ito A, Himeno N. Leucocytozoon caulleryi discovery utilizing indirect-ELISA in East Java, Indonesia as a new approach in detecting leucocytozoonosis. Open Vet. J.. 2025; 15(4): 1557-1564. doi:10.5455/OVJ.2025.v15.i4.6 Vancouver/ICMJE Style Suprihati E, Suwanti LT, Hastutiek P, Lastuti NDR, Ito A, Himeno N. Leucocytozoon caulleryi discovery utilizing indirect-ELISA in East Java, Indonesia as a new approach in detecting leucocytozoonosis. Open Vet. J.. (2025), [cited January 24, 2026]; 15(4): 1557-1564. doi:10.5455/OVJ.2025.v15.i4.6 Harvard Style Suprihati, E., Suwanti, . L. T., Hastutiek, . P., Lastuti, . N. D. R., Ito, . A. & Himeno, . N. (2025) Leucocytozoon caulleryi discovery utilizing indirect-ELISA in East Java, Indonesia as a new approach in detecting leucocytozoonosis. Open Vet. J., 15 (4), 1557-1564. doi:10.5455/OVJ.2025.v15.i4.6 Turabian Style Suprihati, Endang, Lucia Tri Suwanti, Poedji Hastutiek, Nunuk Dyah Retno Lastuti, Akira Ito, and Naomi Himeno. 2025. Leucocytozoon caulleryi discovery utilizing indirect-ELISA in East Java, Indonesia as a new approach in detecting leucocytozoonosis. Open Veterinary Journal, 15 (4), 1557-1564. doi:10.5455/OVJ.2025.v15.i4.6 Chicago Style Suprihati, Endang, Lucia Tri Suwanti, Poedji Hastutiek, Nunuk Dyah Retno Lastuti, Akira Ito, and Naomi Himeno. "Leucocytozoon caulleryi discovery utilizing indirect-ELISA in East Java, Indonesia as a new approach in detecting leucocytozoonosis." Open Veterinary Journal 15 (2025), 1557-1564. doi:10.5455/OVJ.2025.v15.i4.6 MLA (The Modern Language Association) Style Suprihati, Endang, Lucia Tri Suwanti, Poedji Hastutiek, Nunuk Dyah Retno Lastuti, Akira Ito, and Naomi Himeno. "Leucocytozoon caulleryi discovery utilizing indirect-ELISA in East Java, Indonesia as a new approach in detecting leucocytozoonosis." Open Veterinary Journal 15.4 (2025), 1557-1564. Print. doi:10.5455/OVJ.2025.v15.i4.6 APA (American Psychological Association) Style Suprihati, E., Suwanti, . L. T., Hastutiek, . P., Lastuti, . N. D. R., Ito, . A. & Himeno, . N. (2025) Leucocytozoon caulleryi discovery utilizing indirect-ELISA in East Java, Indonesia as a new approach in detecting leucocytozoonosis. Open Veterinary Journal, 15 (4), 1557-1564. doi:10.5455/OVJ.2025.v15.i4.6 |